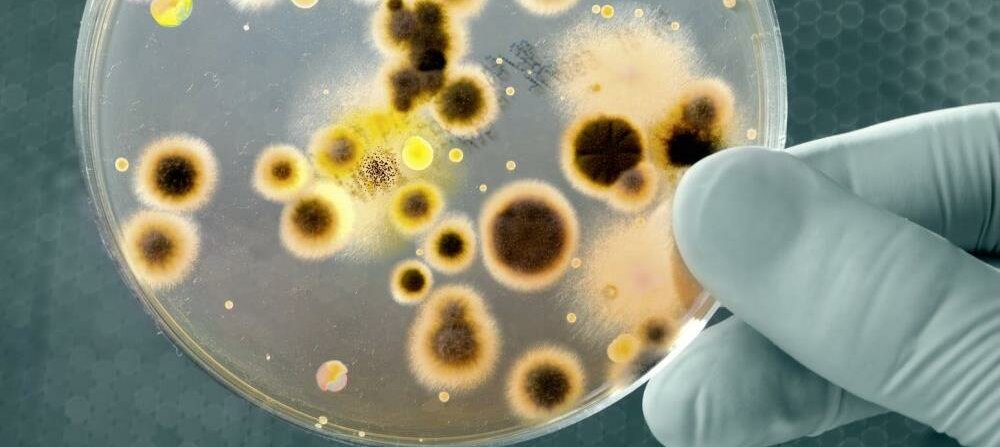

Antibiotika
DIE WUNDERWAFFEN
Seite 1/1 4 Minuten
Sie wirken entweder auf die Zellwand, die Proteinfabriken oder auf die DNA von Bakterien, Strukturen, die es bei menschlichen Zellen nicht gibt oder die sich stark von denen der Mikroorganismen unterscheiden. Durch diese spezifische Wirkung sind Antibiotika in den meisten Fällen gut verträglich.
Für jeden Topf der passende Deckel Bei bakteriellen Infektionen sind Antibiotika Mittel der Wahl, doch nicht jedes Antibiotikum wirkt auch gegen jeden Erreger. So können mit manchen nur grampositive Bakterien, mit anderen wiederum nur gramnegative Bakterien bekämpft werden. Darüber hinaus gibt es Keime, die von Natur aus gegen bestimmte Antibiotika resistent sind, während andere solche Resistenzen erst später erworben haben und deshalb nicht mehr auf den Wirkstoff ansprechen. Daher ist die Bekämpfung von Infektionen mit Antibiotika ein Prozess, in dem die Wirkstoffe ständig weiter entwickelt werden müssen, um effektiv zu bleiben – denn Bakterien sind sehr anpassungsfähige Lebewesen.
Zelle ohne Kern Bakterien kommen in vielen unterschiedlichen Formen vor. Sie können stäbchenoder kugelförmig sein, wie Spiralen oder Korkenzieher aussehen und haben teilweise sehr gegensätzliche Anforderungen an ihre Umgebung. So brauchen etwa manche von ihnen Sauerstoff zum Leben, während er für andere wiederum Gift ist. Doch bei allen Unterschieden ist Bakterien eines gemeinsam: Sie besitzen keinen Zellkern. An seine Stelle tritt das kernähnliche Nukleoid, auch Kernäquivalent genannt. Es ist zwar örtlich fest umgrenzt, aber nicht, wie ein Zellkern, von einer eigenen Membran umschlossen.
»Jedes Bakterium verfügt in seinem Zytoplasma noch über Ribosomen, an denen seine Proteine gebildet werden.«
Das Nukleoid wird von einem ringförmig geschlossenen, doppelsträngigen DNA-Molekül gebildet, dem Bakterienchromosom, das den Großteil der Erbinformation trägt. Darüber hinaus verfügt jedes Bakterium in seinem Zytoplasma noch über Ribosomen, an denen seine Proteine gebildet werden. Dies alles wird von einer Zytoplasmamembran umhüllt, an die sich in den meisten Fällen außen noch eine Zellwand anschließt.
Hemmen oder töten?Antibiotika wirken auf zwei Arten: entweder indem sie nur das Wachstum der Bakterien hemmen oder indem sie die Keime abtöten (bakterizid). Neben diesen beiden Wirkmechanismen unterscheidet man noch verschiedene Wirkgruppen, je nachdem, welchen Teil der Bakterienstruktur das Antibiotikum angreift.
So blockieren Betalactame wie Penicillin spezielle Enzyme, die für den Aufbau der Zellwand aus Murein zuständig sind, einem Polymer aus Zucker und Aminosäuren, das es nur bei Bakterien gibt. Wächst das Bakterium, um sich zu teilen, entstehen aufgrund der Enzymblockade Löcher in der Zellwand. Somit kann Flüssigkeit auf osmotischem Weg ins Bakterium einströmen – bis es irgendwann platzt.
Angriffspunkt DNA Betalactame bilden die größte Gruppe von Antibiotika, sie werden gerade bei Atem- und Harnwegsinfektionen häufig verschrieben. Die Substanzen sind allerdings von Natur aus unwirksam gegen Legionellen und Chlamydien. Gegen diese wiederum helfen Chinolone – Fluorchinolone gegen Legionellen und Chinolone der zweiten Generation gegen Chlamydien. Ihre Wirksamkeit beruht darauf, dass sie nicht wie Betalactame an der Zellwand angreifen, sondern an der DNA.

Bakterien (hier E. Coli) können stäbchen- oder kugelförmig sein, wie Spiralen oder Korkenzieher aussehen und haben teilweise sehr gegensätzliche Anforderungen an ihre Umgebung.
Sie blockieren das Enzym Gyrase, dass dafür zuständig ist, die DNA vor der Teilung des Bakteriums zu entdrillen, sodass sie kopiert werden kann. Funktioniert dieses Entpacken nicht mehr richtig, kann sich das Bakterium nicht teilen und geht aufgrund der inkompletten Replikation der DNA unter.
Der Rundumschlag Eine besondere Bedeutung kommt den Breitbandantibiotika zu, die gegen eine Vielzahl an gramnegativen und grampositiven Keimen wirken. Zu dieser Gruppe zählen neben den Tetracyclinen wie Doxycyclin auch die Makrolide (z. B. Erythromycin). Breitbandantibiotika wirken bakteriostatisch, indem sie die Proteinsynthese an den Ribosomen stören und so die Vermehrung der Bakterien unterbinden. Sie bekämpfen die häufigsten Erreger bakterieller Infektionen wie Streptokokken und Staphylokokken, Durchfallerreger wie Campylobacter, Geschlechtskrankheiten auslösende Neisserien oder auch Chlamydien und Borrelien.
Häufig werden sie eingesetzt, wenn nicht klar ist, welcher Erreger vorliegt oder die Infektion so rasch fortschreitet, dass ein labordiagnostisches Ergebnis nicht abgewartet werden kann. Da man hier nur auf Verdacht behandeln kann, ermöglichen Breitbandantibiotika die größte Trefferquote.
Nicht mit Milch einnehmen! Tetracycline und Chinolone können Komplexe mit Kalzium- und Magnesiumionen bilden, was dazu führt, dass sie vom Körper schlechter aufgenommen werden und somit an Wirksamkeit verlieren. Um dies zu verhindern, sollten daher zwischen der Einnahme von Antibiotika und Milchprodukten oder Magnesiumpräparaten mindestens zwei Stunden liegen. Sie sollten Ihre Kunden auch darauf hinweisen, dass Magnesium nicht nur in Nahrungsergänzungsmitteln sondern zum Beispiel auch in Antazida enthalten ist.
Schädlich für nützliche Bakterien Antibiotika greifen zwar nur Bakterien an und keine menschlichen Zellen, doch befinden sich auf und im Körper eine Vielzahl von Bakterienstämmen, die wir benötigen, um gesund zu bleiben. So spielen Bakterien eine große Rolle in der Verdauung und beim Schutz der Haut. Da eine lange Antibiotikatherapie auch diese nützlichen Bakterien schädigt, kann es zu Hautausschlägen oder Magen-Darm-Beschwerden kommen. Ist die Darmflora nachhaltig gestört, funktioniert die Konkurrenz der Keime nicht mehr und einzelne resistente Bakterien können sich übermäßig vermehren.
Besonders gefürchtet ist dabei das eigentlich harmlose Darmbakterium Clostridium difficile, das Toxine produziert, die bei starkem Befall lebensbedrohlich werden können. Während einer Antibiotikabehandlung sollten Ihre Kunden daher auf eine ausgewogene Kost achten und auch in der Zeit danach noch für die Regeneration der Darmflora sorgen. Dabei helfen können beispielsweise Probiotika, Brottrunk, nicht pasteurisiertes Sauerkraut oder Naturjogurt, nicht jedoch gezuckerte Jogurts, da diese den Darm zusätzlich belasten.
In einigen Fällen kommt es durch die Unverträglichkeit von Antibiotika auch zu Allergien, was besonders bei Penicillin der Fall ist. Die Folgen solcher Allergien können von leichten Hautausschlägen bis hin zum lebensbedrohlichen anaphylaktischen Schock reichen.
Den Artikel finden Sie auch in Die PTA IN DER APOTHEKE 09/14 ab Seite 80.
Dr. Holger Stumpf, Medizinjournalist